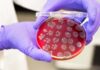
Фекальна трансплантація демонструє обнадійливі результати щодо підвищення ефективності лікування раку

Астрономи ідентифікували планету під назвою HD 137010 b, яка за розміром і орбітальними характеристиками дуже нагадує Землю. Ця нещодавно відкрита планета, розташована на відстані 146 світлових років від нашої Сонячної системи, обертається навколо зірки, схожої на Сонце, і є перспективним об’єктом для майбутніх спостережень.
Відкриття: успіх науки, що підтримується громадянами
Планету вперше виявили в 2017 році за допомогою даних космічного телескопа NASA Kepler. Цікаво, що слабкий сигнал, який вказує на його присутність, вперше помітила група вчених-любителів, включаючи першого автора дослідження доктора Олександра Веннера, коли він ще навчався в середній школі. Це підкреслює зростаючу роль участі громадськості в астрономічних відкриттях.
Ключові характеристики та потенціал життєздатності
За оцінками, HD 137010 b на 6% більший за Землю та має орбітальний період близько 355 днів. Дослідники вважають, що існує 50% ймовірність того, що планета знаходиться в зоні проживання своєї зірки, тобто рідка вода може існувати на її поверхні. Це робить його особливо цікавим кандидатом, оскільки він значно ближчий і яскравіший за інші відомі потенційно населені планети — Kepler-186f, наприклад, у чотири рази далі й набагато слабший.
Холодна реальність: температура поверхні
Незважаючи на свій потенціал для проживання, зірка планети холодніша та тьмяніша за наше Сонце. Це призводить до температури поверхні, приблизно порівнянної з температурою на Марсі, ймовірно, нижче -70°C. Це може бути «суперснігова куля» з потенційно крижаною поверхнею та великою кількістю замерзлої води. Це показує, що «придатний для життя» не обов’язково означає «теплий» або «подібний до Землі».
Майбутні спостереження та підтвердження
Яскравість і близькість зірки роблять HD 137010 b ідеальною мішенню для телескопів нового покоління. Команда впевнена, що це буде одна з перших екзопланет, яку буде детально вивчено, коли передові технології стануть доступними. Однак вчені попереджають, що одного тільки виявлення транзиту недостатньо для підтвердження; зазвичай потрібно три спостереження, щоб остаточно класифікувати екзопланету.
«Це відкриття дуже захоплююче, але потрібні додаткові результати, щоб підтвердити, що це справжня екзопланета». – Доктор Сара Вебб, астрофізик з Університету Свінберна.
Незважаючи на величезну відстань (подорож займе десятки або сотні тисяч років із сучасними технологіями), HD 137010 b є значним кроком до розуміння поширеності землеподібних планет за межами нашої Сонячної системи. Дослідження підкреслює важливість продовження вивчення екзопланет і потенціал для проривних відкриттів.